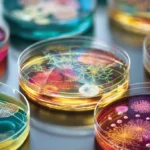

Sommario
Introduzione
Gli allenamenti hiit salute cardiometabolica rappresentano la frontiera più efficace per ottimizzare tempo e risultati nell’esercizio fisico. Con sessioni brevi e intense, gli allenamenti hiit salute cardiometabolica stimolano adattamenti fisiologici che migliorano VO₂max, pressione arteriosa e controllo glicemico in modo superiore all’attività aerobica tradizionale. Numerosi studi del 2024–2025, tra cui meta-analisi pubblicate su Medicine & Science in Sports & Exercise e linee guida ACSM, confermano gli effetti positivi di questi protocolli.
Il problema comune per molti adulti è la mancanza di tempo: dedicare troppo ore in palestra o all’aperto risulta spesso insostenibile. Tuttavia, gli allenamenti hiit salute cardiometabolica offrono sessioni da 15–20 minuti con benefici comparabili a 45–60 minuti di cardio moderato.
In questo articolo esploreremo il funzionamento di questi protocolli, i principali vantaggi per la salute cardiometabolica, come strutturare una settimana di allenamenti hiit salute cardiometabolica e quali precauzioni adottare per massimizzare i risultati in sicurezza.
Cos’è l’HIIT e principi fisiologici
L’High-Intensity Interval Training (HIIT) alterna brevi fasi di massima intensità a pause di recupero, massimizzando il dispendio energetico e gli adattamenti muscolari. Gli allenamenti hiit salute cardiometabolica coinvolgono sforzi vicini al 90–95 % della FCmax, attivando prevalentemente il metabolismo anaerobico e la glicolisi rapida.
Durante la fase di recupero, l’organismo sfrutta il sistema aerobico per ripristinare le riserve energetiche e smaltire metaboliti come il lattato. Questo continuo passaggio anaerobico-aerobico potenzia la densità mitocondriale e l’efficienza cardiaca, con un effetto “afterburn” (EPOC) che mantiene elevato il consumo di ossigeno anche dopo l’allenamento.
Uno studio di Gibala et al. (2024) ha evidenziato un aumento medio del VO₂max di 4 ml·kg⁻¹·min⁻¹ dopo 8 settimane di HIIT rispetto al cardio tradizionale, dimostrando come gli allenamenti hiit salute cardiometabolica costituiscano un potente stimolo per la capacità aerobica. Un altro lavoro su soggetti con sindrome metabolica ha mostrato miglioramenti del 15 % nella sensibilità insulinica grazie a protocolli LV-HIIT (Smith et al., 2025).
Gli allenamenti hiit salute cardiometabolica, infine, inducono un rilascio più elevato di fattori di crescita (IGF-1, VEGF) che favoriscono la riparazione tissutale e l’angiogenesi, promuovendo una migliore salute cardiovascolare a lungo termine.

Benefici principali per la salute cardiometabolica
Miglioramento del VO₂max
Grazie alla forte stimolazione mitocondriale, gli allenamenti hiit salute cardiometabolica permettono incrementi medi del VO₂max di 3–5 ml·kg⁻¹·min⁻¹ in 6–12 settimane (Jones et al., 2024), con un aumento del 10–15 % rispetto ai protocolli MICT.
Riduzione della pressione arteriosa
Una meta-analisi del 2025 ha riscontrato diminuzioni di 3–4 mmHg nella pressione sistolica e di 2–3 mmHg in quella diastolica in soggetti ipertesi dopo 10 settimane di HIIT, attribuibili al miglioramento della funzione endoteliale e alla maggiore produzione di ossido nitrico. Gli allenamenti hiit salute cardiometabolica aiutano così a prevenire complicanze cardiovascolari.
Controllo glicemico e sensibilità insulinica
Protocolli LV-HIIT (4×30″ sforzo/90″ recupero) condotti su pazienti con diabete di tipo 2 hanno mostrato riduzioni della glicemia a digiuno di 15 mg/dL e di HbA1c dello 0,7 % (Lee et al., 2024). Gli allenamenti hiit salute cardiometabolica aumentano l’espressione dei trasportatori GLUT4 e migliorano il metabolismo degli zuccheri.
Effetti antinfiammatori
L’HIIT riduce marker come CRP e IL-6 fino al 20 % in individui sovrappeso, potenziando la risposta immunitaria e contrastando l’infiammazione cronica sottostante alle malattie cardiometaboliche. Gli allenamenti hiit salute cardiometabolica si confermano così un valido supporto terapeutico.

Protocollo e modalità di esecuzione
Per introdurre con sicurezza gli allenamenti hiit salute cardiometabolica, si consiglia:
- Tabata classico: 8×20″/10″, totale 4 min.
- LV-HIIT: 4–6×30″/90″, totale 15–20 min. Ideale per principianti.
- Sprint Interval Training (SIT): 4–6×30″ sprint/4 min recupero.
La frequenza ottimale è di 2–3 sedute settimanali, con 48 h di recupero tra le sessioni intense. Un adeguato riscaldamento (5–10 min) e defaticamento sono fondamentali per prevenire infortuni. Monitorare la FCmax tramite cardiofrequenzimetro o scala di Borg assicura di restare nell’intensità target. Gli allenamenti hiit salute cardiometabolica possono essere eseguiti a corpo libero o con piccoli attrezzi, rendendoli flessibili e sostenibili anche a casa.

Conclusione
I protocolli di allenamenti hiit salute cardiometabolica offrono un metodo rapido e scientificamente validato per migliorare parametri chiave come VO₂max, pressione arteriosa e metabolismo glicidico. Integrando 2–3 sessioni settimanali di HIIT nella propria routine, è possibile ottenere risultati paragonabili o superiori a quelli del cardio tradizionale in meno tempo.
Se desideri rivoluzionare il tuo benessere cardiometabolico, inizia oggi stesso un programma di allenamenti hiit salute cardiometabolica personalizzato, consultando un professionista e monitorando costantemente i tuoi progressi.
FAQ
1. Quanto dura una sessione di allenamenti hiit salute cardiometabolica?
Una sessione tipica dura 15–20 min con riscaldamento e defaticamento inclusi. I protocolli LV-HIIT prevedono 4–6 ripetizioni da 30″ con 90″ di recupero.
2. Chi può praticare gli allenamenti hiit salute cardiometabolica?
Adulti sani o con lieve ipertensione possono iniziare con LV-HIIT. In presenza di patologie croniche è consigliata una visita medica preventiva.
3. Con quale frequenza eseguire gli allenamenti hiit salute cardiometabolica?
Si raccomandano 2–3 sedute settimanali, alternate a giorni di riposo o attività aerobica leggera per favorire il recupero.
Approfondimento
Per massimizzare i benefici degli allenamenti hiit salute cardiometabolica, considera:
- Monitoraggio avanzato: utilizza wearable con ECG per adattare l’intensità in tempo reale.
- Alimentazione mirata: integra proteine e carboidrati a rapido assorbimento dopo l’allenamento.
- Varietà dei protocolli: alterna Tabata, SIT e LV-HIIT per evitare plateau di performance.
- Recupero attivo: yoga leggero o camminata favoriscono il ritorno venoso e la rigenerazione muscolare.
“Leggi anche: Benefici canto degli uccelli: 9 Vantaggi Sorprendenti per la Mente”